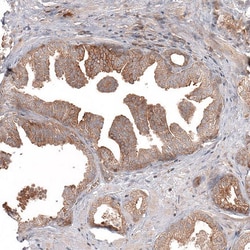
ATG5 Antibody (CL9508) - Azide and BSA Free, Novus Biologicals 100 ul;

missing translation for 'onlineSavingsMsg'
Learn More
Learn More
Beschreibung
ATG5 Monoclonal antibody specifically detects ATG5 in Human samples. It is validated for Western Blot,Immunohistochemistry (Paraffin),Immunohistochemistry

Spezifikation
Spezifikation
| Antigen | ATG5 |
| Anwendungen | Western Blot, Immunohistochemistry (Paraffin), Immunohistochemistry |
| Klassifikation | Monoclonal |
| Klon | CL9508 |
| Konzentration | LYOPH |
| Konjugat | Unconjugated |
| Verdünnung | Western Blot 1 μg/mL, Immunohistochemistry-Paraffin 1:500 - 1:1000 |
| Zusammensetzung | Lyophilized in 5% Trehalose. |
| Gen-Alias | APG5, APG5 (Autophagy 5, S. Cerevisiae)-Like, APG5 autophagy 5-like (S. cerevisiae), APG5L, APG5-LIKE, ASP, ASPAPG5-LIKE, ATG5 Autophagy Related 5 Homolog, ATG5 autophagy related 5 homolog (S. cerevisiae), Autophagy protein 5, Autophagy Related 5, HAPG5, SCAR25 |
| Wirtsspezies | Mouse |
| Mehr anzeigen |
Name des Produkts
Indem Sie auf Absenden klicken, erklären Sie sich damit einverstanden, dass Fisher Scientific sich mit Ihnen in Verbindung setzen kann, um Ihr Feedback in diesem Formular zu bearbeiten. Wir werden Ihre Informationen nicht für andere Zwecke weitergeben. Alle bereitgestellten Kontaktinformationen werden in Übereinstimmung mit unserer Datenschutzrichtlinie aufbewahrt. Datenschutzrichtlinie.
Haben Sie Verbesserungsvorschläge?